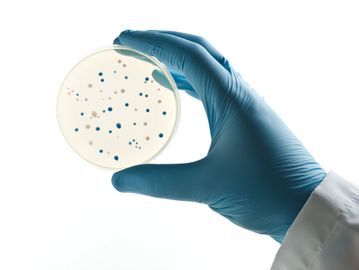

OnDemandBio 제공 서비스
정밀발효 서비스
정밀발효 기반 소재 생산에 필요한 서비스
신규 미생물 동정
Inquiry
고객 수요 맞춤형 신규 기능 미생물 초고속 선별

재조합 플라스미드 제작
Inquiry
클로닝, 발현용, 유전체 편집용 플라스미드 구축
재조합 균주 제작
Inquiry
LMO 고도화, 단백질 발현용 재조합 균주 구축

미생물 시험배양
Inquiry
야생 및 LMO 균주 배양 최적화, 스케일 업 배양

재조합 단백질 발현
Inquiry
다양한 플랫폼 이용 재조합 단백질 발현 서비스

분리정제 서비스
Inquiry
단백질, 당류, 천연물 등 고효율 분리정제법 확립
시험 분석 서비스
미생물, 발효, 식품 위생, 안전성, 유효성 관련 시험 분석 서비스

LMO 균주 안전성 평가
Inquiry
LMO 바이오위해성심사를 위한 시험분석

미생물 인체 위해성 분석
Inquiry
유산균, 장내 미생물 등 NGS 기반 위해성 검토

유해 미생물, 독소 검출
Inquiry
시료 내 병원성 미생물, 곰팡이 독소 등 검출

지표성분 이화학적 분석
Inquiry
시료 내 지표성분, 유효성분 분석 및 신뢰성 평가

유전체, 대사체 분석
Inquiry
미생물 유전체, 전사체, 대사체 분석 서비스

마이크로바이옴 분석
Inquiry
식품, 환경, 개인의 장내 마이크로바이옴 분석
컨설팅 서비스
LMO, 바이오 소재, 식품 원료, 식품 제조 등 인허가 자문

LMO 바이오위해평가
Inquiry
LMO 바이오위해성 심사 컨설팅

식품 인허가
Inquiry
한시적 식품 원료, 식품 첨가물 등 인허가 자문

식품 제조 및 위생관리
Inquiry
식품 유형, 제조 시설, 위생 관리 컨설팅
서비스 관련 문의는 info@ondemandbio.com 으로 메일주세요.
This website uses cookies.
We use cookies to analyze website traffic and optimize your website experience. By accepting our use of cookies, your data will be aggregated with all other user data.